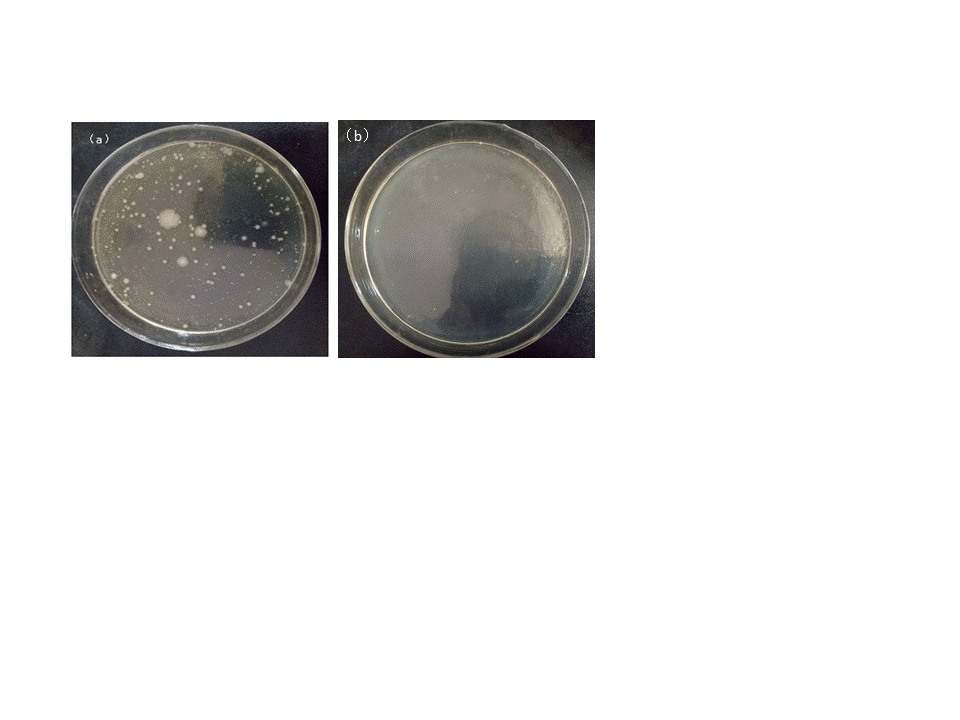

方向二 先进纤维及非织造材料
日期:2020-01-15
点击数:1492
本学科方向致力于高性能、功能性纤维材料的制备和改性,以及新型高端非织造材料与产品开发、工艺和装备设计及其应用方面的理论与技术研究。致力于将纤维开发制备技术与安全防护、生物医疗与交通建筑等前沿学科领域交叉融合,重点开展医学应急防护材料、生物医用植入材料、健康监测传感织物、建筑用高性能纤维及土工材料等领域的研究。拥有交通运输部“青年科技英才”、江苏省“双创人才”、江苏省“333高层次人才工程”、江苏高校“青蓝工程”优秀青年骨干教师等省部级人才16人次。构建了完善的纤维及非织造材料加工测试实验平台,取得了科学研究及产学研合作的显著成效。获国家重点研发计划项目等国家级项目10余项、省部级项目30余项,以及企业委托项目50余项。获中国纺织工业联合会科技进步一等奖、中国产学研创新成果二等奖、江苏省科技进步三等奖等省部级以上科技奖励10余项。在Nanoscale Horizons、Composites Part B等高级别期刊发表论文百余篇,授权国家发明专利30余件。

1.医用抗菌材料


2.防落纤集成清创医用敷料



3.癌细胞抑制功能材料

4.人造皮肤修复图


5.电晕驻极聚丙烯熔喷高效过滤材料

6.交通建筑用多重复合非织造土工材料